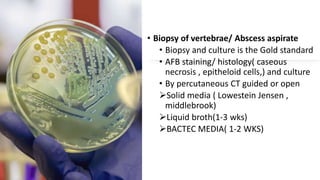
• Biopsy of vertebrae/ Abscess aspirate
• Biopsy and culture is the Gold standard
• AFB staining/ histology( caseous
necrosis , epitheloid cells,) and culture
• By percutaneous CT guided or open
Solid media ( Lowestein Jensen ,
middlebrook)
Liquid broth(1-3 wks)
BACTEC MEDIA( 1-2 WKS)

The document discusses the pathology and management of spinal tuberculosis, a significant public health concern caused by Mycobacterium tuberculosis, which can lead to serious complications like paraplegia and spinal deformity. It outlines the epidemiology, risk factors, diagnostic methods, and treatment protocols, including both medical and surgical approaches, emphasizing the importance of early diagnosis and timely intervention. It also covers various imaging techniques and classifications for better diagnosis and management of the disease.